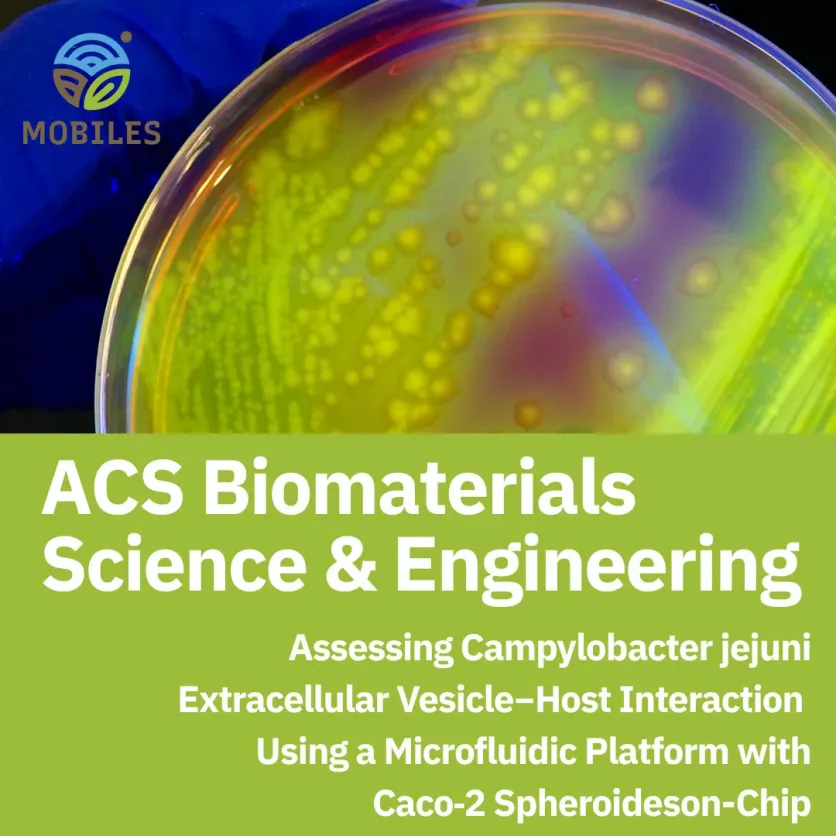
New “Gut-on-a-Chip” Model Sheds Light on Campylobacter Infections

- Event
MOBILES at the 13th International Conference on Sustainable Solid Waste Management (KOS 2026)
The MOBILES consortium is participating at the 13th International Conference on Sustainable Solid Waste Management, held on 24–27 June in Kos, Greece. This conference brings together research on circular materials, biodegradable polymers, wastewater and sludge management, biotechnology, and smart environmental monitoring, areas directly connected to MOBILES’ work on developing sustainable biosensing technologies for detecting pollutants in complex environmental matrices.